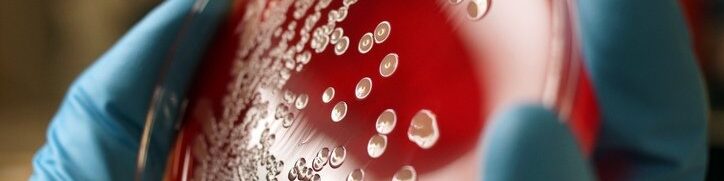

A resistência antimicrobiana (RAM) é o termo empregado por especialistas para denominar o processo através do qual microrganismos como fungos, bactérias, vírus e parasitas sofrem alterações genéticas e deixam de responder a medicamentos que são utilizados para o tratamento de infecções.
Apesar de ser um fenômeno que ocorre naturalmente, a sua intensificação, em virtude do uso excessivo e inadequado de antimicrobianos, tanto para consumo humano e veterinário, quanto na produção agropecuária, é considerada um dos principais problemas a serem enfrentados pelos governos. Embora seja um problema de saúde pública relevante, o Brasil ainda enfrenta desafios para implementar uma estratégia de prevenção e controle.
O tema vem ganhando uma visibilidade maior com o surgimento dos chamados “superfungos” e das “superbactérias”, que são microrganismos resistentes a diferentes classes de antimicrobianos, e que apresentam alta letalidade. Esses termos são usados como uma forma de comunicação da gravidade para o público leigo, mas a sua comparação com um patógeno superpoderoso pode também trazer a ideia de que o problema é um tanto quanto extraordinário, colocando-o distante da realidade da maioria das pessoas.
O que os estudos têm mostrado, no entanto, é um aumento quantitativo e qualitativo na resistência antimicrobiana, pois cada vez mais bactérias de diferentes espécies têm se tornado resistentes a uma série de antibióticos, impactando gravemente a saúde global.
Consequentemente, diversos tipos de infecções se tornam cada vez mais difíceis de serem tratadas, resultando em hospitalizações mais prolongadas, índices de morbidade e mortalidade mais elevados e em um custo financeiro maior para as famílias afetadas e para os serviços de saúde.
Além disso, aumenta o risco e a velocidade de propagação de novos patógenos e possibilita o reaparecimento de doenças em escala global, desafiando os sistemas de saúde a se prepararem para responder de forma rápida e eficiente a essas ameaças.
Um estudo recente sobre o impacto global na saúde da população causado pelas infecções resistentes aos antimicrobianos estima que, em 2019, cerca de 4,95 milhões de pessoas morreram com infecções associadas a bactérias multirresistentes, e 1,27 milhões de pessoas morreram com infecções atribuídas a bactérias multirresistentes.
A crise dos antibióticos
Os antibióticos são os mais utilizados entre os antimicrobianos. A resistência bacteriana a esses medicamentos é atualmente considerada pela Organização Mundial da Saúde (OMS) como a maior e mais urgente ameaça se comparada a outros tipos de resistência, como, por exemplo, a viral ou a fúngica.
A crise gerada pela crescente ineficácia dos antibióticos, associada à falta de investimentos na produção de novos medicamentos, tem sido descrita como o início de uma “era pós-antibiótico”. Alguns dos desafios a serem enfrentados pelos governos são o baixo investimento em pesquisa, desenvolvimento e inovação para a produção de novos antibióticos ou de terapias alternativas.
O principal motivo para o baixo investimento em pesquisa seria o desinteresse da indústria farmacêutica em investir na produção de novos medicamentos em virtude do alto custo de produção e da pouca lucratividade. No caso dos antibióticos, seu uso terapêutico ocorre de maneira mais curta se comparado com medicamentos para doenças crônicas, por exemplo.
Além disso, quanto mais esses medicamentos são utilizados, mais rápido a resistência se desenvolve e eles se tornam ineficientes para tratar as infecções. Esse cenário tem provocado muita discussão e pouco consenso entre governos, financiadores e organizações multilaterais em torno dos possíveis modelos de financiamento e incentivos ao mercado farmacêutico.
Estratégias de prevenção e controle da resistência antimicrobiana
As estratégias de prevenção e controle são essenciais neste contexto. Há um consenso entre a comunidade científica e autoridades sanitárias de que, para isso, deve ser considerado o fortalecimento de políticas e programas de controle e prevenção de infecções; a adoção de medidas que regularizem e orientem as práticas de prescrição, uso, dispensação e descarte de antibióticos; e a promoção e o fortalecimento de programas de vacinação. O monitoramento do uso de antibióticos e da resistência também é de extrema importância para identificar patógenos resistentes e evitar a propagação de surtos.
Em 2015, a OMS lançou o Plano de Ação Global (GAP) para o Enfrentamento à Resistência aos Antimicrobianos. O objetivo era estabelecer diretrizes para o desenvolvimento de planos de ação nacionais baseados na abordagem da Saúde Única, com ações conjuntas nos campos da saúde humana, animal e ambiental. Apesar do Plano ter incentivado estratégias nacionais, diversos estudos têm alertado para o baixo progresso nas suas implementações, sobretudo nos países de baixo e médio desenvolvimento econômico e social.
No Brasil, o Plano de Ação Nacional de Prevenção e Controle da Resistência aos Antimicrobianos no Âmbito da Saúde Única (PAN-BR) representou um avanço em termos da formalização de uma agenda de Saúde Única para tratar o tema. No entanto, resultados de uma pesquisa revelam inúmeros desafios para a governança da RAM no Brasil.
Um dos maiores desafios é tornar o problema da resistência antimicrobiana visível como um problema de saúde pública no país. Para que isso ocorra, é necessário trazer à tona de forma mais explícita os impactos clínicos, sociais e econômicos, ampliando o debate por meio de pesquisas multidisciplinares que indicam estratégias de comunicação, divulgação, disseminação dos resultados e tradução dos conhecimentos para o público geral de forma mais efetiva.
Junto a isto, é importante construir a agenda política por meio do diálogo mais amplo com a sociedade e do engajamento de usuários dos serviços, gestores, profissionais de saúde, formuladores de políticas e com os diversos atores que desempenham um papel importante na extensa cadeia que envolve o uso de antibióticos, incluindo o setor agropecuário.
Além disso, é necessário alinhar e articular a política em todos os níveis de atenção à saúde e nas esferas federal, estadual e municipal, para que as prioridades nacionais e as necessidades regionais do Sistema Único de Saúde (SUS) sejam contempladas na governança da RAM no Brasil.
Por fim, embora o enfrentamento à crise demande ações de controle e diminuição do uso de antibióticos, não se pode ignorar que no Brasil, assim como em outros países do Sul Global, persiste a desigualdade no acesso aos medicamentos. A maioria das pessoas ainda morre mais pela falta de acesso ao antibiótico correto do que pela resistência antimicrobiana. Desta forma, não se trata apenas de reduzir o uso em qualquer circunstância, mas de promover um equilíbrio entre o acesso oportuno para quem precisa e prevenção do uso excessivo e inadequado.
*O artigo foi escrito pela pesquisadora de pós-doutorado em saúde pública Juliana Côrrea, da Escola de Administração de Empresas de São Paulo da Fundação Getúlio Vargas (FGV/EAESP), e publicado na plataforma The Conversation Brasil.
Fonte: Metrópoles